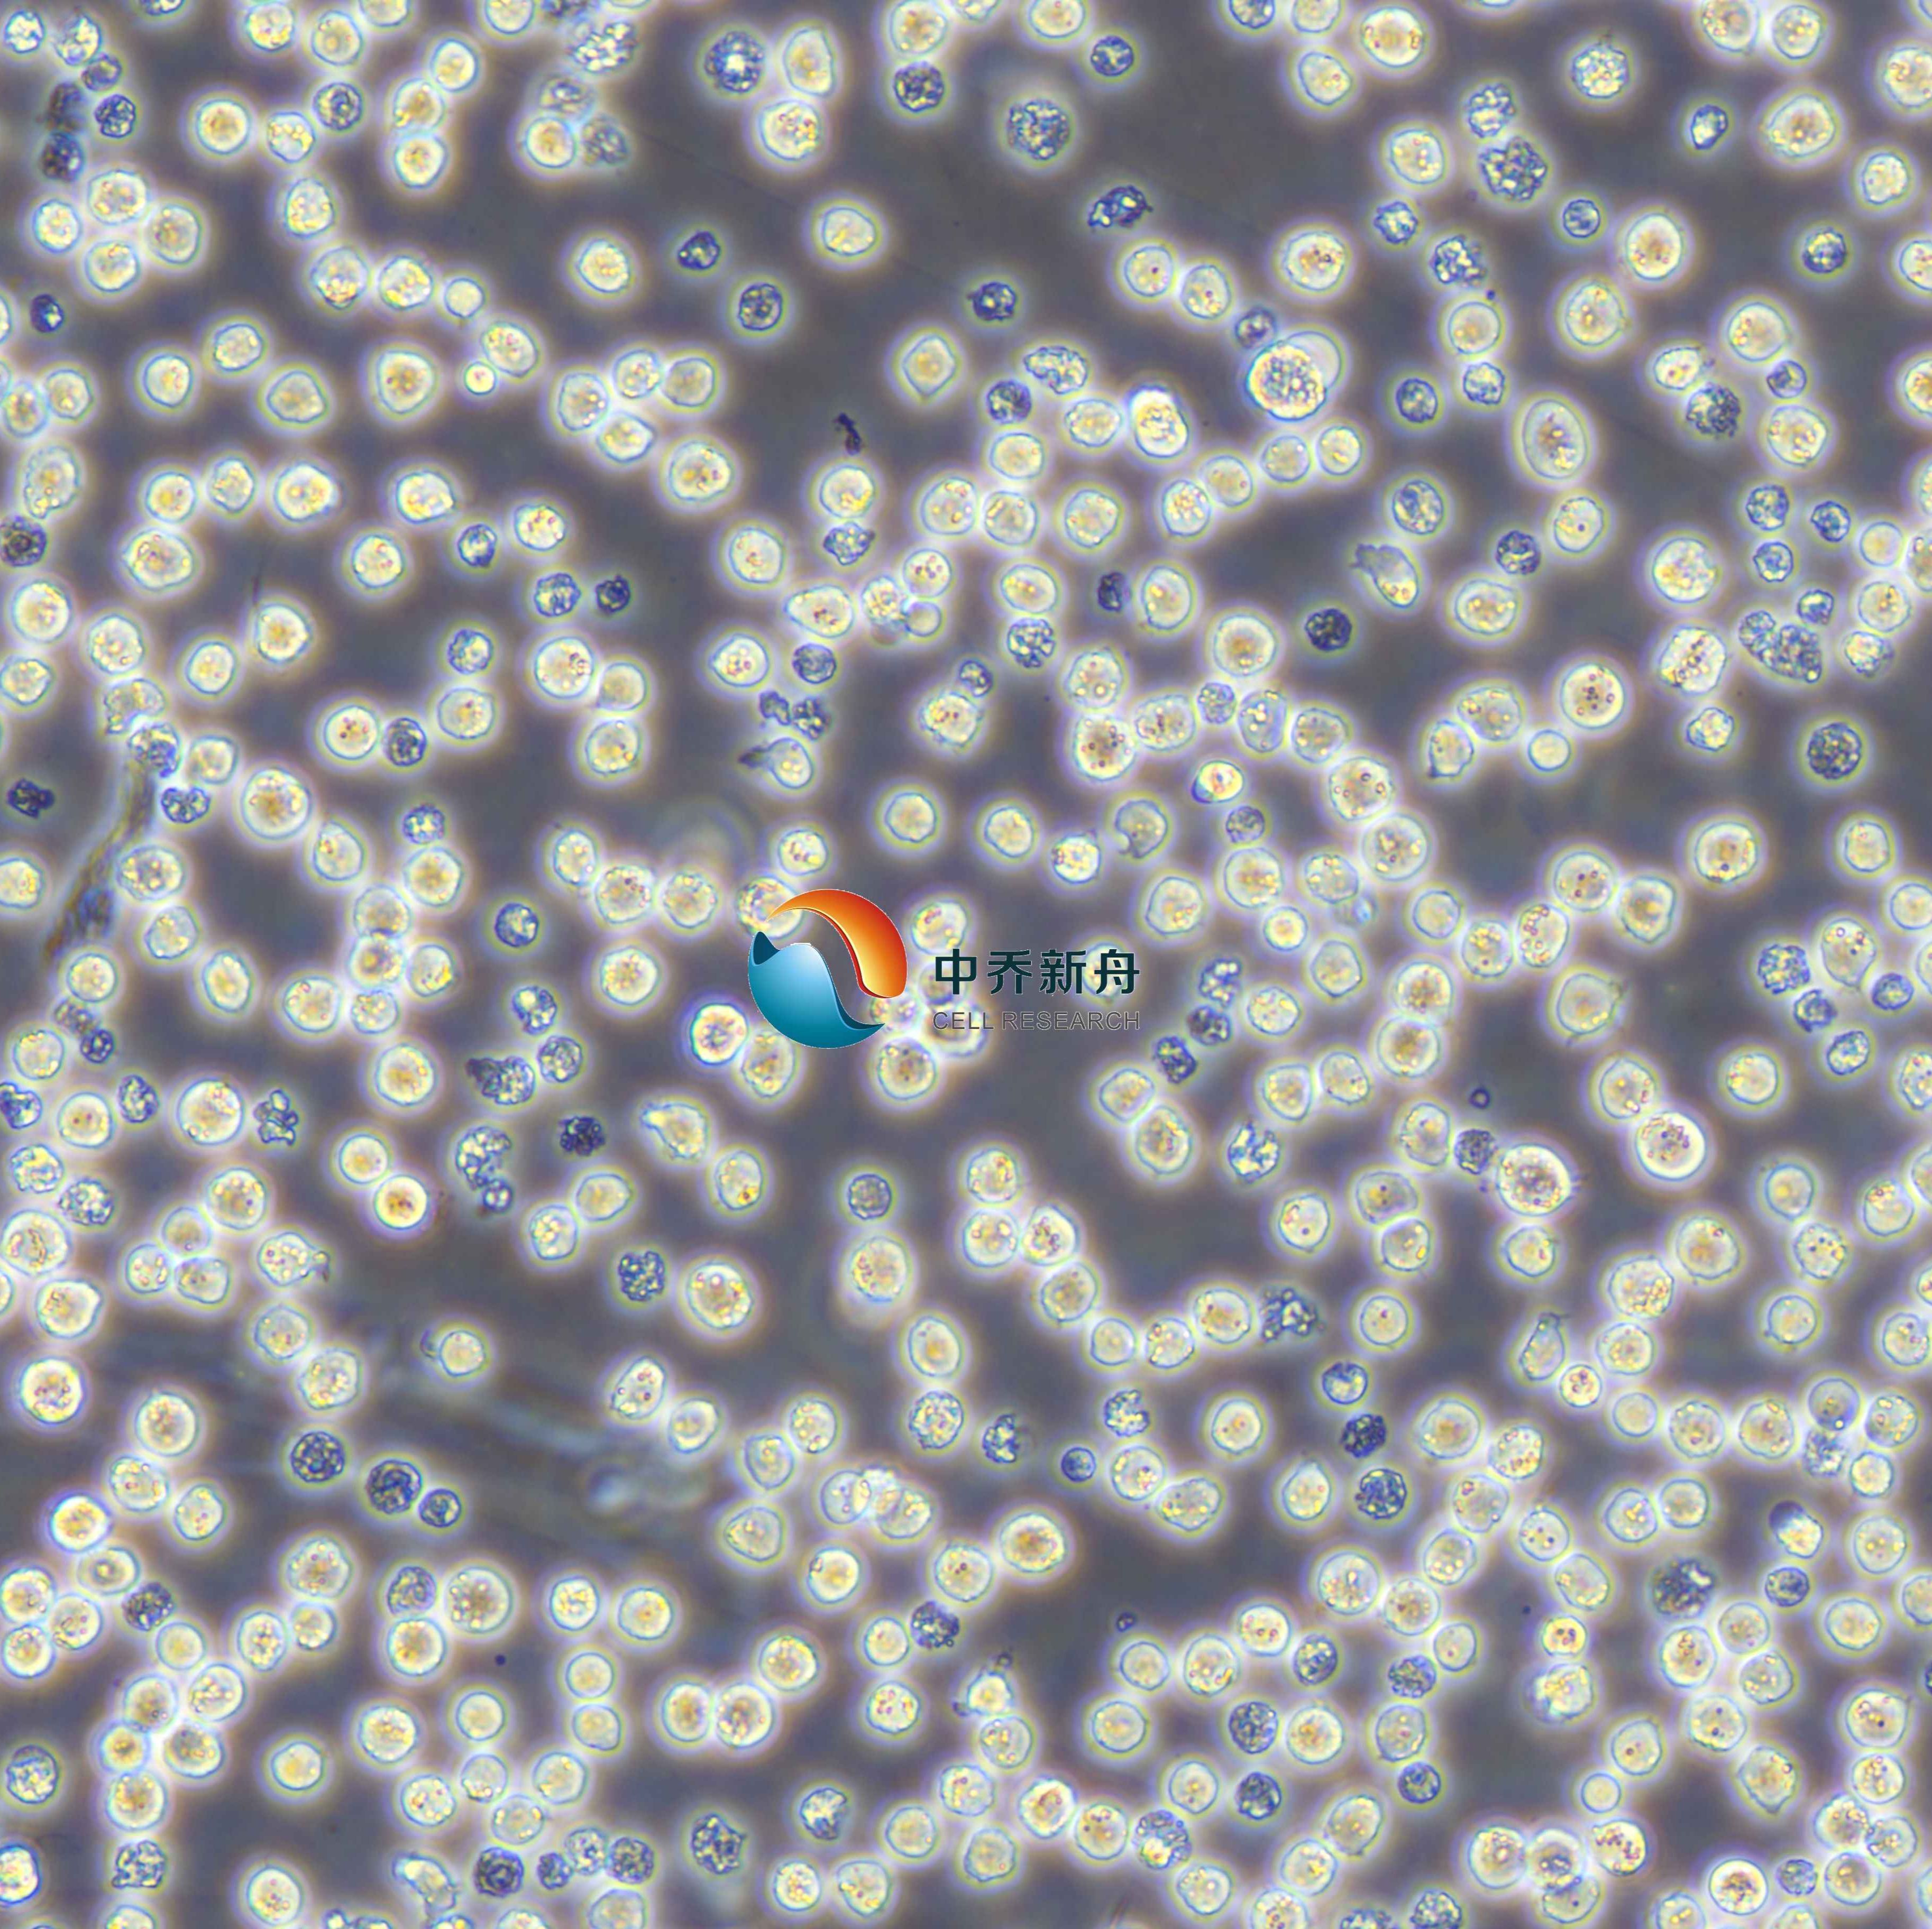
产品封面图

万千商家帮你免费找货
0 人在求购买到急需产品
- 详细信息
- 文献和实验
- 技术资料
- 英文名:
HL-60
- 库存:
大量
- 供应商:
中乔新舟
- 细胞类型:
细胞系
- 品系:
human
- 组织来源:
human
- 相关疾病:
否
- 物种来源:
human
- 免疫类型:
否
- 细胞形态:
咨询销售
- 器官来源:
human
- 运输方式:
T25瓶运输
- 年限:
5-10年
- 生长状态:
悬浮生长
- 规格:
5 x 10^5 cells/vial
|
产品名称 |
HL-60人原髓细胞白血病细胞 |
|
货号 |
ZQ0433 |
|
产品介绍 |
HL-60是一株早幼粒细胞。 外周血白细胞来自一位患有急性粒-单核细胞白血病的36岁白人女性。 HL-60 自发分化,丁酸盐、次黄嘌呤、佛波醇肉豆蔻酸(PMA,TPA)、DMSO(1% to 1.5%)、 细胞表现出吞噬活性,并对趋化刺激有响应。致癌基因myc表达阳性。 |
|
种属 |
人 |
|
性别/年龄 |
女/36岁 |
|
组织 |
外周血 |
|
疾病 |
急性早幼粒细胞白血病 |
|
细胞类型 |
肿瘤细胞 |
|
形态学 |
淋巴母细胞样 |
|
生长方式 |
悬浮 |
|
倍增时间 |
大约16~40小时 |
|
培养基和添加剂 |
IMDM(品牌:中乔新舟 货号:ZQ-900)+20%胎牛血清(中乔新舟 货号:ZQ0500)+1%P/S(中乔新舟 货号:CSP006) |
|
推荐完全培养基货号 |
ZM0433 |
|
生物安全等级 |
BSL-1 |
|
STR位点信息 |
D5S818: 12 |
|
培养条件 |
95%空气,5%二氧化碳;37℃ |
|
抗原表达/受体表达 |
Complement, expressed; Fc, expressed |
|
基因表达 |
tumor necrosis factor (TNF), also known as tumor necrosis factor alpha (TNF-alpha, TNF alpha), after stimulation with phorbol myristic acid; myc+ |
|
保藏机构 |
ATCC; CCL-240 BCRC; 60027 BCRJ; 0104 DSMZ; ACC-3 ECACC; 98070106 |
|
供应限制 |
仅供科研使用 |
上海中乔新舟生物科技有限公司成立于2011年,历经十多年发展,主要专注于细胞生物学产品的研究和开发,专注于为药企、各类科研机构及CRO企业提供符合标准规范的细胞培养服务、细胞培养基、细胞检测试剂盒、细胞培养试剂,胎牛血清和细胞生物学技术服务等。
公司一直致力于为高等院校、研究机构、医院、CRO及CDMO企业提供细胞培养完整解决方案,这些产品旨在满足细胞培养的多样需求,确保实验和研究的有效进行。引用中乔新舟(ZQXZBIO)产品和服务的文献超数千篇。

产品服务
细胞资源:原代细胞、细胞株、干细胞、示踪细胞、耐药株细胞、永生化细胞等基因工程细胞。
试剂产品:胎牛血清、完全培养基(适用于原代细胞及细胞株)、无血清培养基、基础培养基、细胞转染试剂、重组因子、胰酶和双抗等等细胞培养所有实验相关产品。
技术服务:稳转株构建、原代细胞分离、特殊培养基定制服务、细胞检测等。

目前产品已经畅销国内30多个省市,与客户建立长期的合作伙伴关系,共同实现成功。全体员工将不懈努力,继续为科研人员提供优良的产品和服务,致力成为全球细胞培养领域的参与者。

企业愿景
致力于成为国内细胞培养基产业的佼佼者,生物医药领域上游原材料的优良提供商。
企业使命
成长为专业细胞系及原代细胞培养供应商、专业细胞培养基及培养试剂生产商。
企业荣誉


风险提示:丁香通仅作为第三方平台,为商家信息发布提供平台空间。用户咨询产品时请注意保护个人信息及财产安全,合理判断,谨慎选购商品,商家和用户对交易行为负责。对于医疗器械类产品,请先查证核实企业经营资质和医疗器械产品注册证情况。
文献和实验1、论文标题: Overexpression of MYCT1 Inhibits Proliferation and Induces Apoptosis in Human Acute Myeloid Leukemia HL-60 and KG-1a Cells in vitro and in vivo
DOI: 10.3389/fphar.2018.01045
发表时间: 2018-09-18
期刊: Frontiers in Pharmacology
影响因子: 5.811
货号: ZQ0433
产品名称: HL-60 cells
2、PubMed=29491412; DOI=10.1038/s41388-018-0150-2
Gerlach D., Tontsch-Grunt U., Baum A., Popow J., Scharn D., Hofmann M.H., Engelhardt H., Kaya O., Beck J., Schweifer N., Gerstberger T., Zuber J., Savarese F., Kraut N.
The novel BET bromodomain inhibitor BI 894999 represses super-enhancer-associated transcription and synergizes with CDK9 inhibition in AML.
Oncogene 37:2687-2701(2018)
3、PubMed=30285677; DOI=10.1186/s12885-018-4840-5
Tan K.-T., Ding L.-W., Sun Q.-Y., Lao Z.-T., Chien W., Ren X., Xiao J.-F., Loh X.-Y., Xu L., Lill M., Mayakonda A., Lin D.-C., Yang H., Koeffler H.P.
Profiling the B/T cell receptor repertoire of lymphocyte derived cell lines.
BMC Cancer 18:940.1-940.13(2018)
4、PubMed=30629668; DOI=10.1371/journal.pone.0210404
Uphoff C.C., Pommerenke C., Denkmann S.A., Drexler H.G.
Screening human cell lines for viral infections applying RNA-Seq data analysis.
PLoS ONE 14:E0210404-E0210404(2019)
5、PubMed=30670178; DOI=10.1016/j.jcf.2018.06.007
Jennings S., Ng H.P., Wang G.-S.
Establishment of a DeltaF508-CF promyelocytic cell line for cystic fibrosis research and drug screening.
J. Cyst. Fibros. 18:44-53(2019)
6、PubMed=30894373; DOI=10.1158/0008-5472.CAN-18-2747
Dutil J., Chen Z.-H., Monteiro A.N.A., Teer J.K., Eschrich S.A.
An interactive resource to probe genetic diversity and estimated ancestry in cancer cell lines.
Cancer Res. 79:1263-1273(2019)
7、PubMed=31068700; DOI=10.1038/s41586-019-1186-3
Ghandi M., Huang F.W., Jane-Valbuena J., Kryukov G.V., Lo C.C., McDonald E.R. III, Barretina J.G., Gelfand E.T., Bielski C.M., Li H.-X., Hu K., Andreev-Drakhlin A.Y., Kim J., Hess J.M., Haas B.J., Aguet F., Weir B.A., Rothberg M.V., Paolella B.R., Lawrence M.S., Akbani R., Lu Y.-L., Tiv H.L., Gokhale P.C., de Weck A., Mansour A.A., Oh C., Shih J., Hadi K., Rosen Y., Bistline J., Venkatesan K., Reddy A., Sonkin D., Liu M., Lehar J., Korn J.M., Porter D.A., Jones M.D., Golji J., Caponigro G., Taylor J.E., Dunning C.M., Creech A.L., Warren A.C., McFarland J.M., Zamanighomi M., Kauffmann A., Stransky N., Imielinski M., Maruvka Y.E., Cherniack A.D., Tsherniak A., Vazquez F., Jaffe J.D., Lane A.A., Weinstock D.M., Johannessen C.M., Morrissey M.P., Stegmeier F., Schlegel R., Hahn W.C., Getz G., Mills G.B., Boehm J.S., Golub T.R., Garraway L.A., Sellers W.R.
Next-generation characterization of the Cancer Cell Line Encyclopedia.
Nature 569:503-508(2019)
8、PubMed=31160637; DOI=10.1038/s41598-019-44491-x
Quentmeier H., Pommerenke C., Dirks W.G., Eberth S., Koeppel M., MacLeod R.A.F., Nagel S., Steube K., Uphoff C.C., Drexler H.G.
The LL-100 panel: 100 cell lines for blood cancer studies.
Sci. Rep. 9:8218-8218(2019)
9、PubMed=33389257; DOI=10.1007/s10096-020-04106-0
Wurtz N., Penant G., Jardot P., Duclos N., La Scola B.
Culture of SARS-CoV-2 in a panel of laboratory cell lines, permissivity, and differences in growth profile.
Eur. J. Clin. Microbiol. Infect. Dis. 40:477-484(2021)
10、PubMed=35839778; DOI=10.1016/j.ccell.2022.06.010
Goncalves E., Poulos R.C., Cai Z.-X., Barthorpe S., Manda S.S., Lucas N., Beck A., Bucio-Noble D., Dausmann M., Hall C., Hecker M., Koh J., Lightfoot H., Mahboob S., Mali I., Morris J., Richardson L., Seneviratne A.J., Shepherd R., Sykes E., Thomas F., Valentini S., Williams S.G., Wu Y.-X., Xavier D., MacKenzie K.L., Hains P.G., Tully B., Robinson P.J., Zhong Q., Garnett M.J., Reddel R.R.
Pan-cancer proteomic map of 949 human cell lines.
Cancer Cell 40:835-849.e8(2022)
Cell Reports:浙大蒋晞课题组发文揭示阿片受体激动剂调控白血病表观遗传学修饰的新机制
through both catalytic and non-catalytic functions of TET2 的研究论文。该研究报道以洛哌丁胺(易蒙停)为代表的阿片受体激动剂在急性髓细胞性白血病(Acute myeloid leukemia, AML)中的潜在疗效,及其调控 TET 介导的 DNA 修饰的分子机制及信号通路。 为了明确 AML 发病过程中涉及到的信号转导通路,作者对细胞表面最大的受体超家族(G protein-coupled receptors (GPCRs))的激动剂和拮抗剂进行了小分子化合物筛选,发现阿片
为ALL。现已证明这是在体内受化疗的影响,这也表明少数病例可能是一种疾病的2种期。系列转变常在诊断后6月内转变,这与继发性白血病不同,后者常需3~10年。目前规定急性混合细胞白血病的诊断标准是:淋系细胞要从形态学、细胞化学(PAS、ACP、TdT)、淋巴细胞系表面抗原(单克隆抗体)、TcR基因重排或免疫球蛋白重链(IgH)基因重排来诊断;髓系细胞要从形态学(Auer小体),细胞化学(MPO、SB、CE、NSE)、髓细胞系表面抗原(髓系单抗)来证明。 1、 形态学检查:可见粒细胞样原始细胞
癌 CHMas 肥大细胞白血病 SGC-790 胃腺癌 HEL 红细胞白血病 (Erythroleukemia) BGC-823 低分化胃腺癌 HL-60 原髓细胞白血病 (Promyelocytic lenukemia) MKN-45 低分化胃癌 K562 慢性髓原白血病 (chronic myelogenous leukemia) LoVo 结肠腺癌 Hut-78 皮肤T细胞淋巴瘤 Ls-174-T 结肠腺癌 Hut-102 皮肤T细胞
技术资料暂无技术资料 索取技术资料